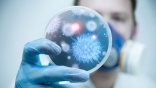
Are sanitary bin liner consumables protecting users, asks Genesis Biosciences

Home › magazine › latest news › 2016
Speakers announced for the IFRA UK Fragrance Forum
19th of August 2016The fragrance association IFRA UK has announced details of its 2016 Fragrance Forum, which will take place on October 12 at the Royal Society in London.
This year it has invited a group of speakers to explore fragrance, wellness and wellbeing, considering the effects of aroma on health both now and in the past.
Dr Mark Evans is a lecturer in
Toilet tours offered in London
18th of August 2016Two toilet tours are currently being offered in London in a bid to inform and entertain participants about everything relating to the British public lavatory.
London Loo Tours take in various interesting toilets while delving into the history of public health in England and looking at how a growing understanding of the spread of disease has led
New research highlights need to abandon modern hygiene hypothesis
17th of August 2016The July issue of Perspectives in Public Health (published by the Royal Society of Public Health) takes an objective view of ongoing research showing the hygiene hypothesis - the idea that allergies are the price we are paying for our "modern obsession with cleanliness" - is a misleading misnomer.
Not only does it undermine attitudes to hygiene
Sodexo Ireland president included on Cranfield’s Women to Watch list
16th of August 2016Sodexo's country president for Ireland, Margot Slattery, has been included in Cranfield Management School's 100 Women to Watch list for 2016. The service provider's global ceo for corporate services Sylvia Metayer is also included in the list.
Cranfield's Women to Watch list was first created in 2009. Showcasing the female talent pool in the UK,
Are sanitary bin liner consumables protecting users, asks Genesis Biosciences
15th of August 2016Biosciences company Genesis Biosciences is asking for more in-depth scientific data to support claims made for ‘antimicrobial' consumables used within sanitary bin services.
With on-site liner exchange services, sanitary waste bin liners are often complimented with an antimicrobial consumable which acts as a disinfectant to protect users
Clinical trials confirm 'no-touch disinfection' properties of copper
12th of August 2016Recently-published research from a joint US-Chile clinical trial studying the contribution of antimicrobial copper touch surfaces to environmental hygiene in a paediatric intensive care unit describes the intervention as a ‘no-touch disinfection technology' that warrants serious consideration as part of a bundle of infection prevention